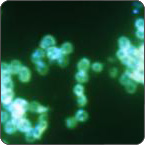

We humans like to think that we are rather powerful, and we are, in our own way. But pound for pound, gonorrhea is a far mightier beast. Also known as “the clap,” these tiny creatures can pull with a force equal to 100,000 times their body weight. What would this equate to in humans? Well, it would be as though a human could drag 10 million kilos (22 million pounds).
What is the secret to this great strength? Scientists have long known that bacteria produce filaments called pili. These pili are amazingly tiny when compared to human standards, but they are amazingly big compared to gonorrhea. In fact, these are up to ten times longer than the bacterium itself. They can also contract, and (of course) the bacteria use this ability to their advantage. Ultimately, Neisseria gonorhoeae bacteria use “type four” pili to crawl along a surface and to attach to cells and infect them (not so fun times for the infected).
However, what scientists didn’t know is that this bacteria can bundle pili together (essentially linking them as a unit) to exert long (and strong) pulls.
In 2008, Michael Sheetz and colleagues at Columbia University discovered this amazing feat by placing the bacteria in a field of tiny gel “pillars” and measuring the amount the bacteria could bend them.Electron microscopic images confirmed what scientists were witnessing in the videos i.e., that gonorrhea could link their pili together to exert force. This research also revealed why scientists have not seen this link-and-pull method before, it is because a protein usually added to the bacterial culture medium happens to block it.
It may sound pretty terrifying, but remember, gonorrhea isn’t actually our size (thankfully).
Still, these tiny monsters are something to be taken rather seriously. For starters, this is a very common infectious disease. The Center for Disease Control (the CDC) estimates that, each year, over 800,000 people in the United States alone get new gonorrhea infections. Staggeringly, less than half of these infections are detected and reported to CDC. All in all, in 2012, 334,826 cases of gonorrhea were reported to CDC.
And sadly, untreated gonorrhea can cause serious and permanent health problems in both women and men (this does not bode well for the hundreds of thousands of individuals who contract the disease each year and are unaware). If gonorrhea is untreated (or if the medical regime is not competed), it may spread locally, which can leas to epididymitis or pelvic inflammatory disease (which can cause serious complication with pregnancy). If not treated for a length of time, it may spread throughout the body via blood, affecting joints and heart valves. Even more unfortunate, gonorrhea has progressively developed resistance to the antibiotic drugs prescribed to treat it. So even when it is detected, it is becoming harder to treat. And with nearly a million news cases each year in the U.S. alone, we all need to be concerned about antibiotic resistance and ensure that we are properly tested. Currently, we have few antibiotic options left that are simple, well-studied, well-tolerated, and highly effective.
Even more horrifying? Human experiments were conducted by the United States in Guatemala from 1946 to 1948 to find a cure for gonorrhea. Information about these experiments was not discovered until rather recently (within the last 10 years). The research was uncovered by Professor Susan Mokotoff Reverby of Wellesley College. Reverby found the documents in 2005 and brought the information to light. These experiments were conducted under the administration of President Harry S. Truman and President Juan José Arévalo (both administrations were aware of the testing). Doctors infected a series of individuals (including soldiers, prostitutes, prisoners, and mental patients) without the informed consent of the subjects. The purpose seemed to be to test the effectiveness of penicillin in combating gonorrhea and other sexually transmitted diseases. Ultimately, this led to at least 83 deaths.